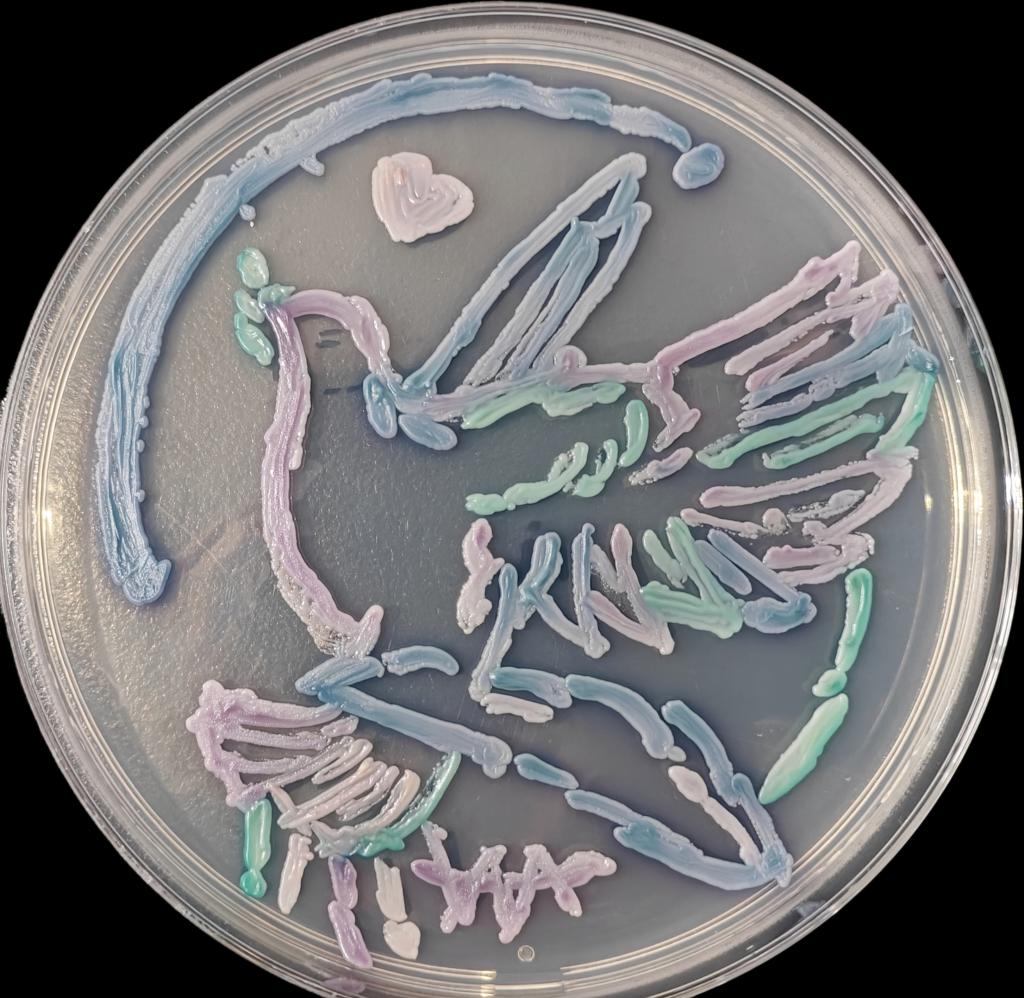
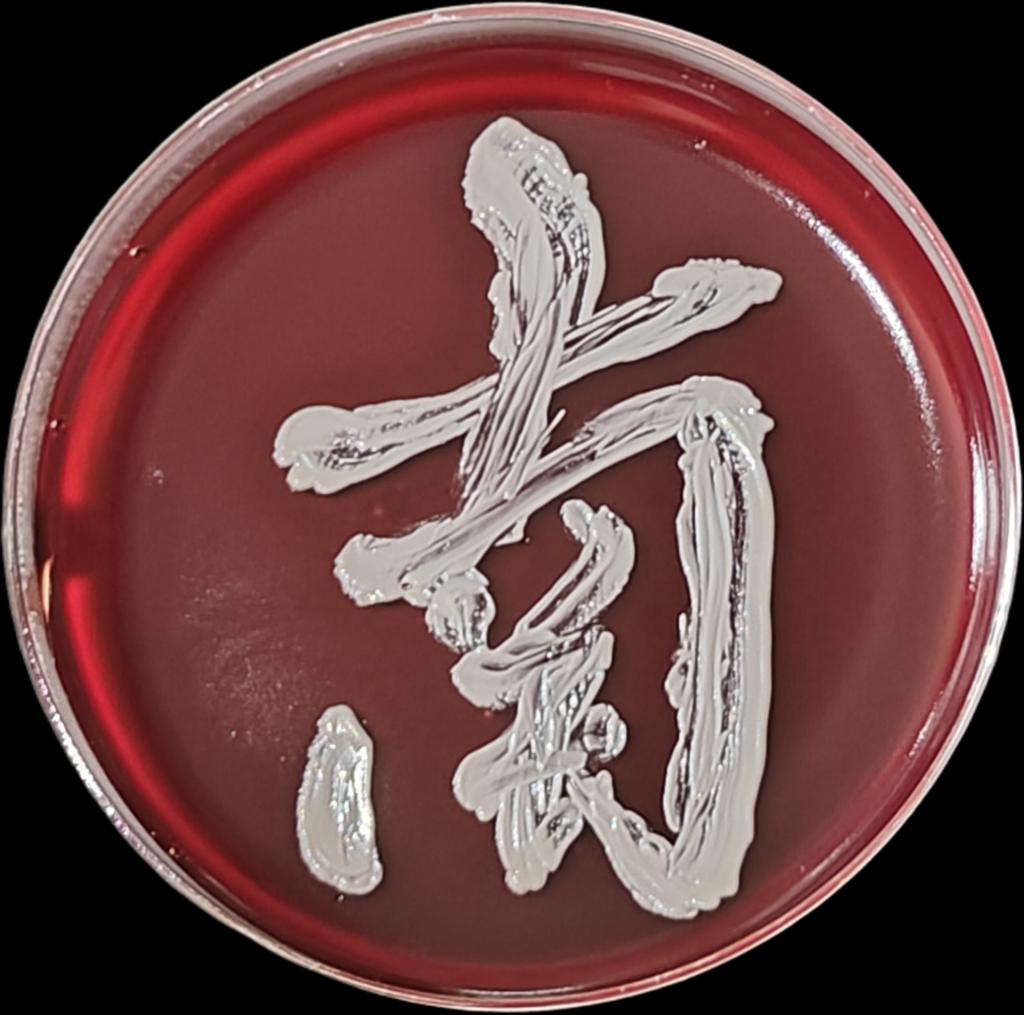
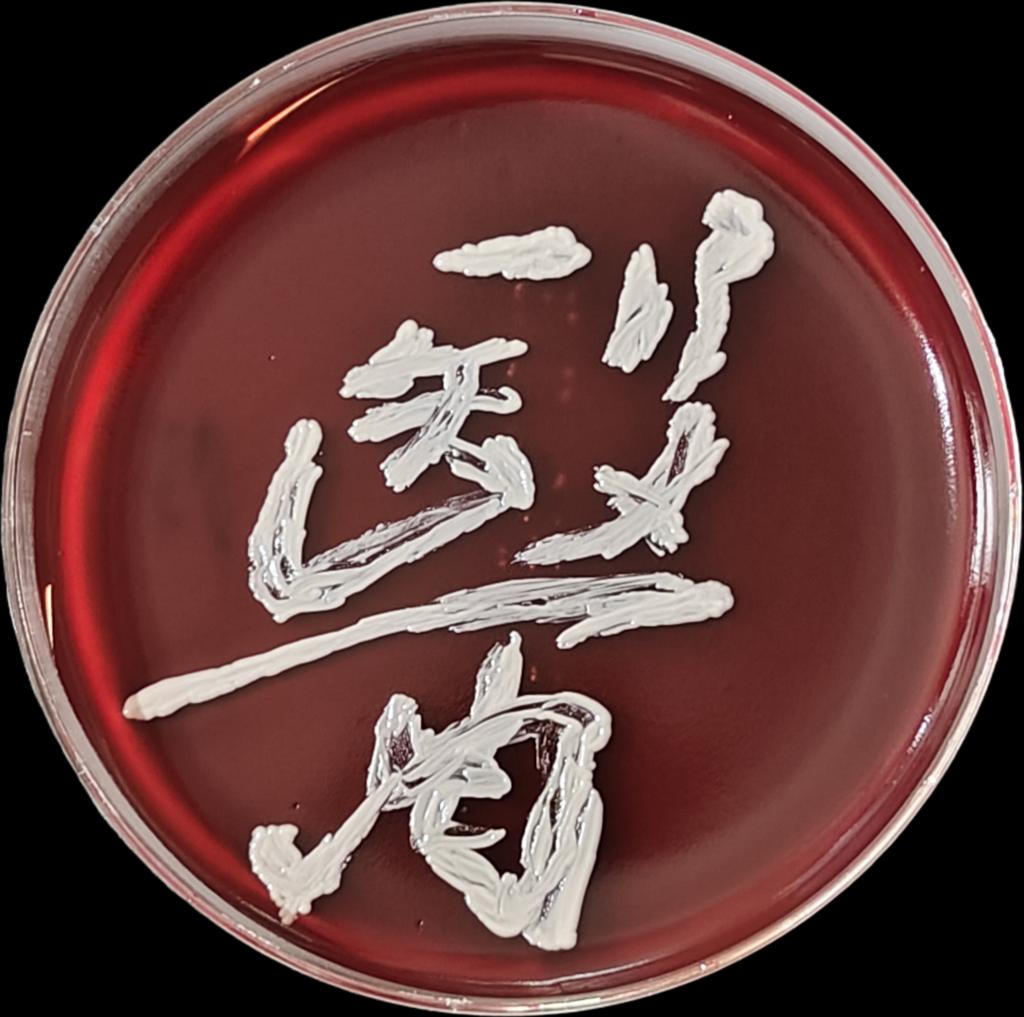
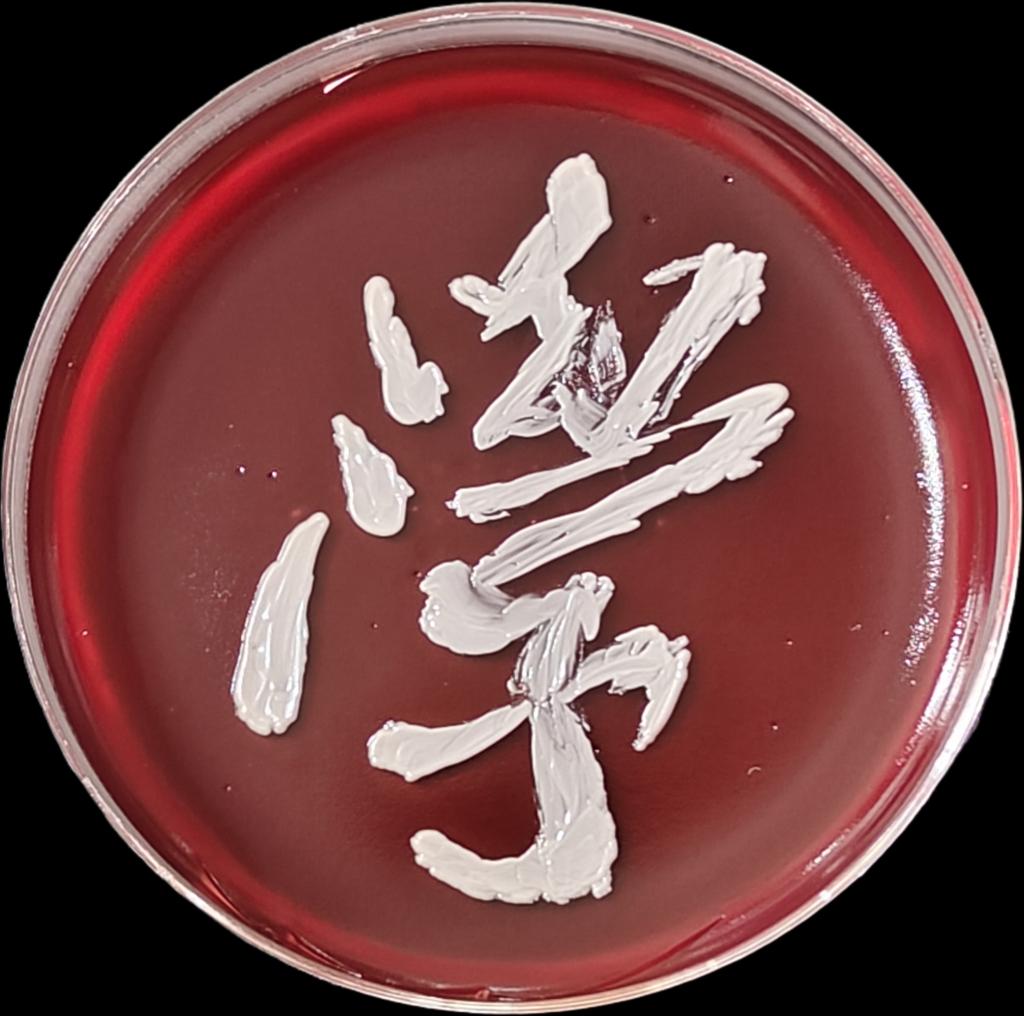
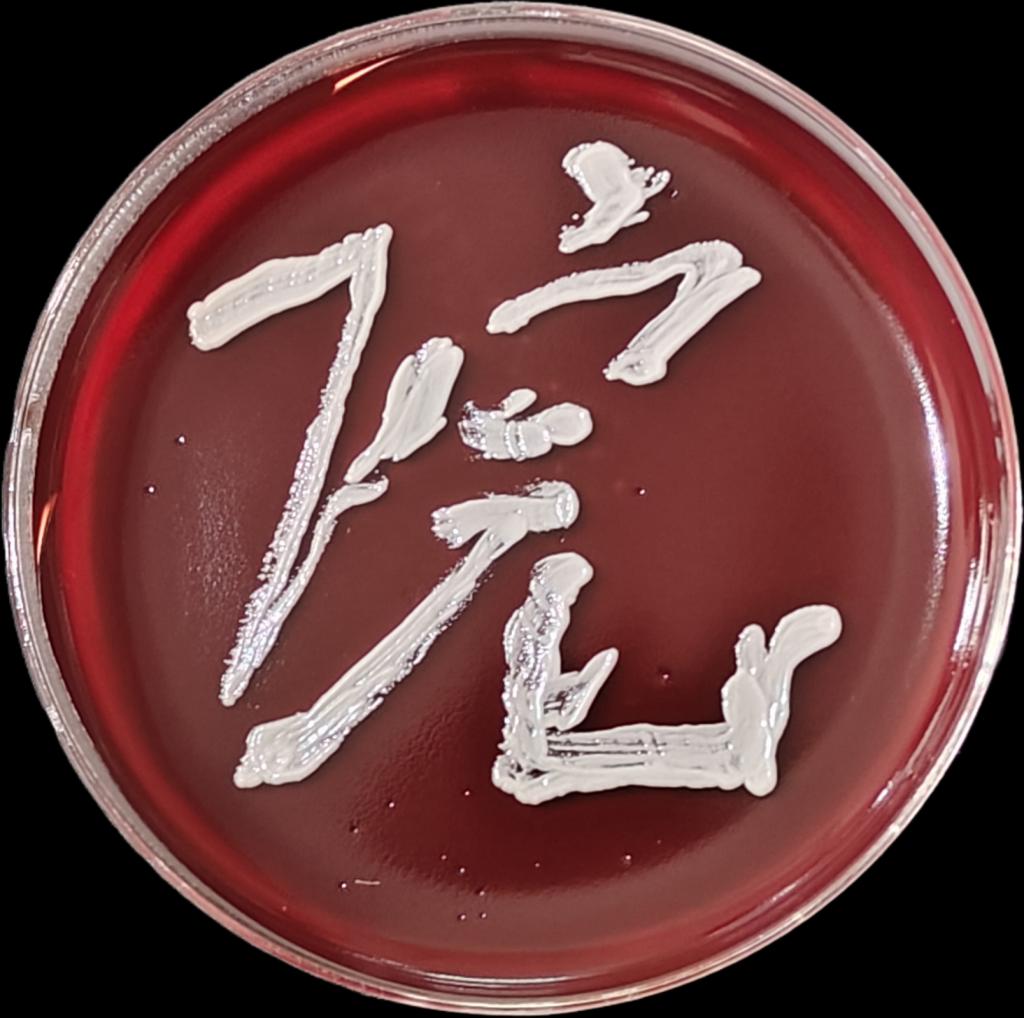
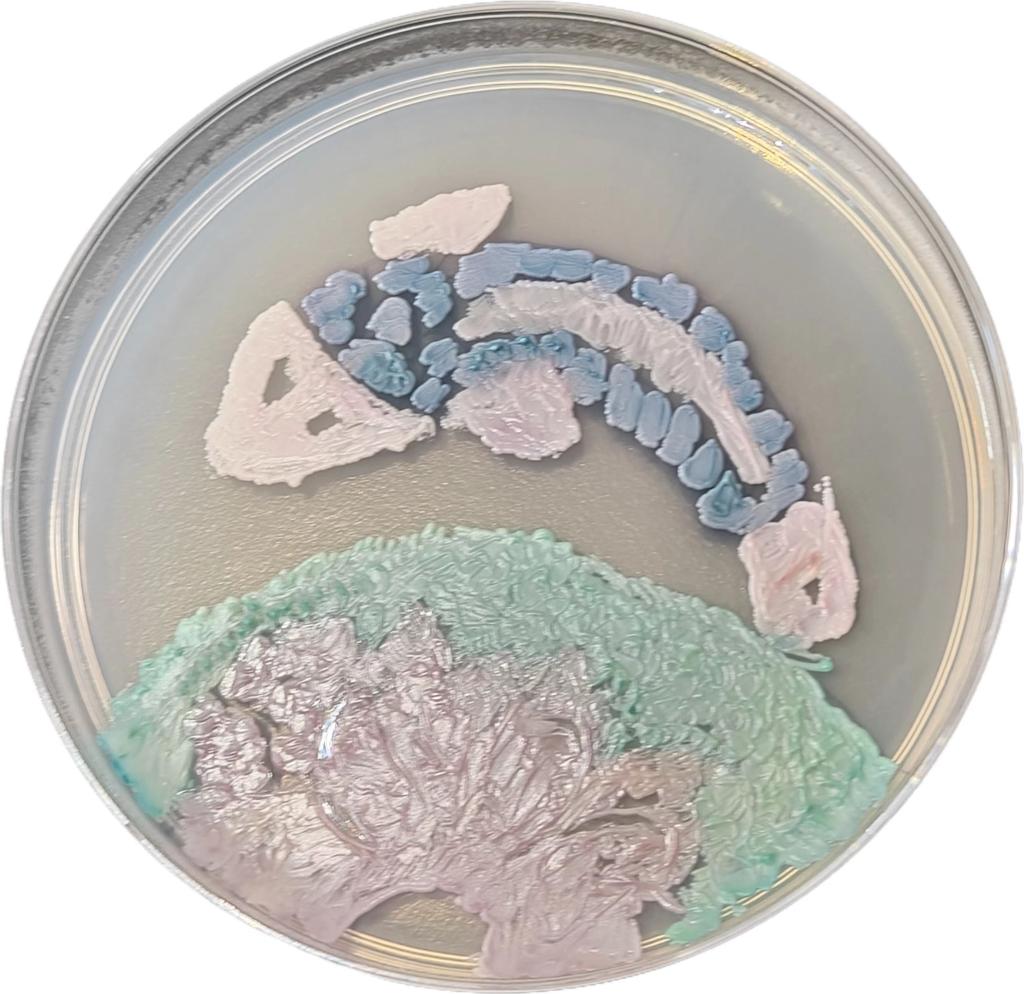
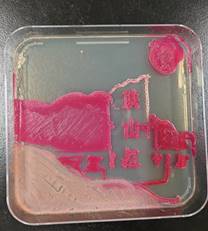

为庆祝中华人民共和国成立75周年,深入学习贯彻习近平新时代中国特色社会主义思想,落实立德树人根本任务,以党建引领公司高质量发展,全方位推进大思政铸魂育人工程,十大体育网站教工党支部于11至12月举办第二届微生物培养皿艺术设计大赛,培养青年老员工科学精神,推动微生物学知识科普,展示微生物多姿多彩的“微”美世界,促进科学、人文与艺术融合,激发老员工钻研科学的志趣,提升老员工科学实践能力,让课堂成为推进老员工思想政治教育的主阵地。
本次比赛共有50多个团队或个人、100余名同学报名参赛,共提交作品66幅。公司组织专家对参赛作品从主题创意、专业技术及艺术效果等不同层面进行了细致的综合评价,最终评选出个人特等奖1幅,一等奖作品2幅、二等奖5幅、三等奖15幅,优秀奖15幅。

微生物培养皿艺术又称“琼脂艺术”,是以琼脂平皿为画布、微生物为颜料,经适当培育后,利用微生物在不同平皿培养基上生长后展示出的不同颜色及菌落特征来进行作品的艺术加工和创作。琼脂艺术是融医学、艺术和人文为一体的科学实践和新兴艺术形式。
艺术需要精雕细琢,医学需要严谨求实。“只有在艺术与医学紧密结合的氛围中,医员工才能体会到艺术人文与医学的巧妙融合,感受到医学的魅力”。教工党支部的党员教师们在两个月的比赛时间里不分白昼和节假日坚持工作在实验室,为员工修改设计图、培训实验技术、采购和制备培养基、消毒环境和器材、整理和编辑所有的参赛资料,做出了无私奉献。参赛同学利用课外时间坚持在实验室里进行方案设计、培养条件摸索、绘制术技术练习、作品调整和优化。多才多艺的同学们将自己的书法、绘画、剪纸、摄影等方面的天赋,及扎实的微生物学的基本知识和熟练培养技术充分展示出来,所创作的部分作品精美绝伦、让指导老师和评委赞叹不已。同时,在创作过程中,同学们也展现出医员工持之以恒、严谨求实、团结协作的精神风貌。
本次大赛依托省级一流本科课程《临床微生物学检验技术》,把专业知识、实验操作与课程思政、科研启蒙深度融合。十大体育网站教工党支部将继续以学科专业竞赛为切入点,以课程实验激发员工科研兴趣、以综合实践增加乐趣、以项目实训培养志趣,打通学科专业竞赛育人通路,积极构建“科研+思政”教育协同育人模式。依托微世界艺术大赛,教工党支部将不断强化思想政治引领,提高员工的人文素养、科学素养,培养员工勇于创新的科研精神和精益求精的工匠精神,培养具有家国情怀,有责任、有担当的医学人才和社会主义接班人,为推动社会主义现代化建设贡献青春之力!

附:获奖作品展示

特等奖:24检验1班 张博琳团队 辉煌百年史,激荡奋进路

一等奖:23级临床3班 周菲娜团队 一带一路


一等奖:22检验3班 徐静颖 醒狮
二等奖:22检验3班 刘旭团队 和平

二等奖:22检验1班 刘苛团队

二等奖:22检验1班 曾宇茜团队

二等奖:22检验1班 王梦琳团队

三等奖:24级临床9班 丁向灿 纪念白求恩
三等奖:24口医1班 李文怡 鱼戏彩莲上
三等奖:23级临床3班 郑钰睿 映山红